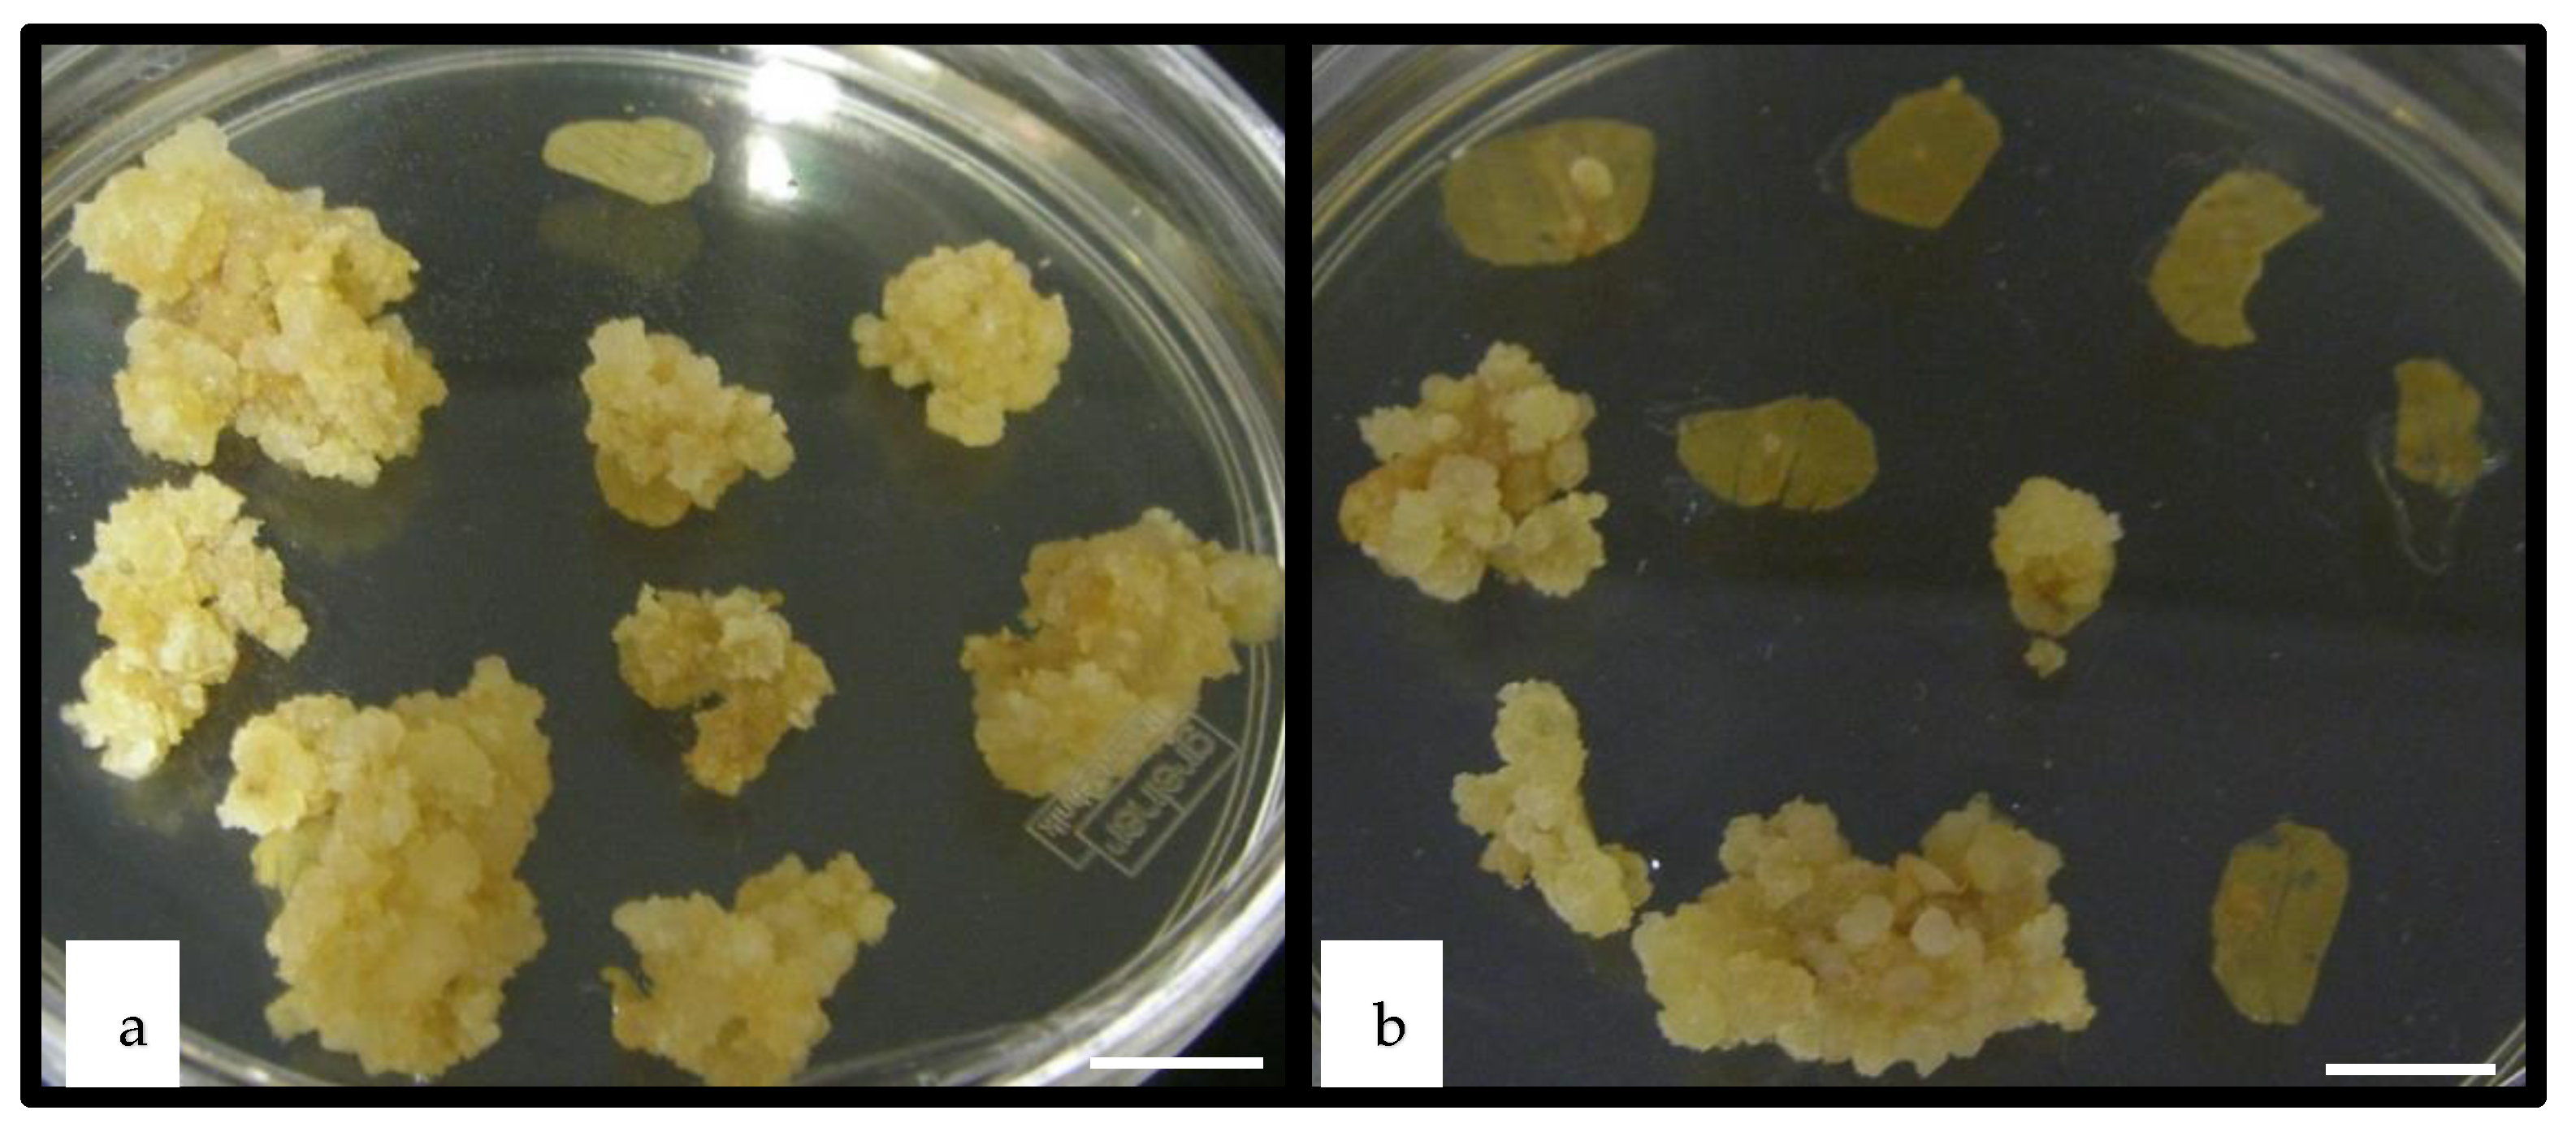

WUSCHEL Overexpression Promotes Callogenesis and Somatic Embryogenesis in Medicago truncatula Gaertn
Abstract
1. Introduction
2. Results
2.1. The Designed Construct Allows WUS Gene Expression but Not Induction by Jasmonate
2.2. WUSCHEL Enhances Callogenesis in M. truncatula Leaf Explants
2.3. WUSCHEL Enhances Embryogenesis in M. truncatula Leaf Explants
2.4. WUSCHEL Enhances Callogenesis in M. truncatula Hairy Root (HR) Explants
2.5. WUSCHEL Enhances Embryogenesis in M. truncatula HR Explants
2.6. Embryo Development and Plantlet Production
3. Discussion
4. Materials and Methods
4.1. Construction of Binary Plasmids
4.2. Bacterial Strains and Growth Conditions
4.3. Agrobacterium tumefaciens-Mediated Leaf Transformation of M. truncatula
4.4. Coculture and Culture Media of M. truncatula Leaves
4.5. Agrobacterium rhizogenes-Mediated Hairy Root Production in M. truncatula
4.6. Culture Media of M. truncatula Hairy Roots
4.7. Induction of WUS Transgene Expression
4.8. Molecular Analysis, Polymerase Chain Reaction (PCR) Analysis
4.9. Real-Time PCR (qRT-PCR) Analysis
4.10. Histology and Microscopy
4.11. Statistical Analysis
5. Conclusions
Author Contributions
Funding
Institutional Review Board Statement
Informed Consent Statement
Data Availability Statement
Conflicts of Interest
References
- Gulzar, B.; Mujib, A.; Malik, M.Q.; Sayeed, R.; Mamgain, J.; Ejaz, B. Genes, proteins and other networks regulating somatic embryogenesis in plants. J. Genet. Eng. Biotechnol. 2020, 18, 31. [Google Scholar] [CrossRef] [PubMed]
- Méndez-Hernández, H.A.; Ledezma-Rodríguez, M.; Avilez-Montalvo, R.N.; Juárez-Gómez, Y.L.; Skeete, A.; Avilez-Montalvo, J.; De-La-Peña, C.; Loyola-Vargas, V.M. Signaling overview of plant somatic embryogenesis. Front. Plant Sci. 2019, 10, 1–15. [Google Scholar] [CrossRef]
- Nic-Can, G.I.; Loyola-Vargas, V.M. The role of the auxins during somatic embryogenesis. In Somatic Embryogenesis. Fundamental Aspects and Applications; Loyola-Vargas, V.M., Ochoa-Alejo, N., Eds.; Springer: Cham, Switzerland, 2016; pp. 171–181. [Google Scholar] [CrossRef]
- Stone, S.L.; Kwong, L.W.; Yee, K.M.; Pelletier, J.; Lepiniec, L.; Fisher, R.L.; Goldberg, R.B.; Harada, J.J. LEAFY COTYLEDON2 encodes a B3 domain transcription factor that induces embryo development. Proc. Natl. Acad. Sci. USA 2001, 98, 11806–11811. [Google Scholar] [CrossRef]
- Hecht, V.; Vielle Calzada, J.P.; Hartog, M.V.; Schmidt, E.D.; Boutilier, K.; Grossniklaus, U.; de Vries, S.C. The Arabidopsis SOMATIC EMBRYOGENESIS RECEPTOR KINASE 1 gene is expressed in developing ovules and embryos and enhances embryogenic competence in culture. Plant Physiol. 2001, 127, 803–816. [Google Scholar] [CrossRef]
- Boutilier, K.; Offringa, R.; Sharma, V.K.; Kieft, H.; Ouellet, T.; Zhang, L.; Hattori, J.; Liu, C.M.; van Lammeren, A.A.; Miki, B.L.; et al. Ectopic expression of BABY BOOM triggers a conversion from vegetative to embryonic growth. Plant Cell 2002, 14, 1737–1749. [Google Scholar] [CrossRef] [PubMed]
- Laux, T.; Mayer, K.F.; Berger, J.; Jurgens, G. The WUSCHEL gene is required for shoot and floral meristem integrity in Arabidopsis. Development 1996, 122, 87–96. [Google Scholar]
- Lotan, T.; Ohto, M.; Yee, K.M.; West, M.A.; Lo, R.; Kwong, R.W.; Yamagishi, K.; Fischer, R.L.; Goldberg, R.B.; Harada, J.J. Arabidopsis LEAFY COTYLEDON1 is sufficient to induce embryo development in vegetative cells. Cell 1998, 93, 1195–1205. [Google Scholar] [CrossRef]
- Wójcikowska, B.; Jaskóła, K.; Gąsiorek, P.; Meus, M.; Nowak, K.; Gaj, M.D. LEAFY COTYLEDON2 (LEC2) promotes embryogenic induction in somatic tissues of Arabidopsis, via YUCCA-mediated auxin biosynthesis. Planta 2013, 238, 425–440. [Google Scholar] [CrossRef]
- Zuo, J.; Niu, Q.W.; Frugis, G.; Chua, N.H. The WUSCHEL gene promotes vegetative-to-embryonic transition in Arabidopsis. Plant J. 2002, 30, 349–359. [Google Scholar] [CrossRef] [PubMed]
- Wang, X.; Niu, Q.W.; Teng, C.; Li, C.; Mu, J.; Chua, N.H.; Zuo, J. Overexpression of PGA37/MYB118 and MYB115 promotes vegetative-to-embryonic transition in Arabidopsis. Cell Res. 2009, 19, 224–235. [Google Scholar] [CrossRef]
- Tsuwamoto, R.; Yokoi, S.; Takahata, Y. Arabidopsis EMBRYOMAKER encoding an AP2 domain transcription factor plays a key role in developmental change from vegetative to embryonic phase. Plant Mol. Biol. 2010, 73, 481–492. [Google Scholar] [CrossRef]
- Srinivasan, C.; Liu, Z.; Heidmann, I.; Supena, E.N.J.; Fukuoka, H.; Joosen, R.; Lambalk, J.; Angenent, G.; Scorza, R.; Custers, J.B.M.; et al. Heterologous expression of the BABY BOOM AP2/ERF transcription factor enhances the regeneration capacity of tobacco (Nicotiana tabacum L). Planta 2007, 225, 341–351. [Google Scholar] [CrossRef]
- Heidmann, I.; de Lange, B.; Lambalk, J.; Angenent, G.C.; Boutilier, K. Efficient sweet pepper transformation mediated by the BABY BOOM transcription factor. Plant Cell Rep. 2011, 30, 1107–1115. [Google Scholar] [CrossRef]
- Florez, S.L.; Erwin, R.L.; Maximova, S.N.; Guiltinan, M.J.; Curtis, W.R. Enhanced somatic embryogenesis in Theobroma cacao using the homologous BABY BOOM transcription factor. BMC Plant Biol. 2015, 15, 121–133. [Google Scholar] [CrossRef]
- Khanday, I.; Santos-Medellin, C.; Sundaresan, V. Rice embryogenic trigger BABY BOOMI promotes somatic embryogenesis by Upregulation of auxin biosynthesis genes. bioRxiv 2020. [Google Scholar] [CrossRef]
- Guo, F.; Liu, C.; Xia, H.; Bi, Y.; Zhao, C.; Zhao, S.; Hou, L.; Li, F.; Wang, X. Induced expression of AtLEC1 and AtLEC2 differentially promotes somatic embryogenesis in transgenic tobacco plants. PLoS ONE 2013, 8, e71714. [Google Scholar] [CrossRef]
- Harding, E.W.; Tang, W.; Nichols, K.W.; Fernandez, D.E.; Perry, S.E. Expression and maintenance of embryogenic potential is enhanced through constitutive expression of AGAMOUS-Like 15. Plant Physiol. 2003, 133, 653–663. [Google Scholar] [CrossRef] [PubMed]
- Lowe, K.; Wu, E.; Wang, N.; Hoerster, G.; Hastings, C.; Cho, M.J.; Scelonge, C.; Lenderts, B.; Chamberlin, M.; Cushatt, J.; et al. Morphogenic regulators Baby boom and Wuschel improve monocot transformation. Plant Cell 2016, 28, 1998–2015. [Google Scholar] [CrossRef]
- Haecker, A.; Gross-Hardt, R.; Geiges, B.; Sarkar, A.; Breuninger, H.; Herrmann, M.; Laux, T. Expression dynamics of WOX genes mark cell fate decisions during early embryonic patterning in Arabidopsis thaliana. Development 2004, 131, 657–668. [Google Scholar] [CrossRef] [PubMed]
- Tadege, M. WOX3 in the scene: Intimacy with hormones. J. Exp. Bot. 2016, 67, 1605–1607. [Google Scholar] [CrossRef][Green Version]
- Ikeda, M.; Takahashi, M.; Fujiwara, S.; Mitsuda, N.; Ohme-Takagi, M. Improving the efficiency of adventitious shoot induction and somatic embryogenesis via modification of WUSCHEL and LEAFY COTYLEDON 1. Plants 2020, 9, 1434. [Google Scholar] [CrossRef] [PubMed]
- Mayer, K.F.; Schoof, H.; Haecker, A.; Lenhard, M.; Jurgens, G.; Laux, T. Role of WUSCHEL in regulating stem cell fate in the Arabidopsis shoot meristem. Cell 1998, 95, 805–815. [Google Scholar] [CrossRef]
- Gallois, J.L.; Nora, F.R.; Mizukami, Y.; Sablowski, R. WUSCHEL induces shoot stem cell activity and developmental plasticity in the root meristem. Genes Dev. 2004, 18, 375–380. [Google Scholar] [CrossRef]
- Chen, S.K.; Kurdyukov, S.; Kereszt, A.; Wang, X.D.; Gresshoff, P.M.; Rose, R.J. The association of homeobox gene expression with stem cell formation and morphogenesis in cultured. M. truncatula. Planta 2009, 230, 827–840. [Google Scholar] [CrossRef]
- Zhao, P.; Begcy, K.; Dresselhaus, T.; Sun, M.X. Does early embryogenesis in eudicots and monocots involve the same mechanism and molecular players? Plant Physiol. 2017, 173, 130–142. [Google Scholar] [CrossRef] [PubMed]
- Rashid, S.Z.; Yamaji, N.; Kyo, M. Shoot formation from root tip region: A developmental alteration by WUS in transgenic tobacco. Plant Cell Rep. 2007, 26, 1449–1455. [Google Scholar] [CrossRef] [PubMed]
- Arroyo-Herrera, A.; Ku-Gonzalez, A.; Canche-Moo, R.; Quiroz-Figueroa, F.R.; Loyola-Vargas, V.M.; Rodriguez-Zapata, L.C.; D’Hondt, C.B.; Suárez-Solís, V.M.; Castaño, E. Expression of WUSCHEL in Coffea canephora causes ectopic morphogenesis and increases somatic embryogenesis. Plant Cell Tissue Organ. Cult. 2008, 94, 171–180. [Google Scholar] [CrossRef]
- Solís-Ramos, L.Y.; González-Estrada, T.; Nahuath-Dzib, S.; Zapata-Rodriguez, L.C.; Castaño, E. Overexpression of WUSCHEL in C. chinense causes ectopic morphogenesi. Plant Cell Tissue Organ. Cult. 2009, 96, 279–287. [Google Scholar] [CrossRef]
- Klimaszewska, K.; Pelletier, G.; Overton, C.; Stewart, D.; Rutledge, R.G. Hormonally regulated overexpression of Arabidopsis WUS and conifer LEC1 (CHAP3A) in transgenic white spruce: Impli-cations for somatic embryo development and somatic seedling growth. Plant Cell Rep. 2010, 29, 723–734. [Google Scholar] [CrossRef]
- Bouchabke-Coussa, O.; Obellianne, M.; Linderme, D.; Montes, E.; Maia-Grondard, A.; Vilaine, F.; Pannetier, C. Wuschel overexpression promotes somatic embryogenesis and induces organogenesis in cotton (Gossypium hirsutum L.) tissues cultured in vitro. Plant Cell Rep. 2013, 32, 675–686. [Google Scholar] [CrossRef]
- Tvorogova, V.E.; Fedorova, Y.E.; Potsenkovskaya, E.A.; Kudriashov, A.A.; Efremova, E.P.; Kvitkovskaya, V.A.; Wolabu, T.W.; Zhang, F.; Tadege, M.; Lutova, L.A. The WUSCHEL-related homeobox transcription factor MtWOX9-1 stimulates somatic embryogenesis in Medicago truncatula. Plant Cell Tissue Organ Cult. 2019, 3, 517–527. [Google Scholar] [CrossRef]
- Zheng, W.; Zhang, X.; Yang, Z.; Wu, J.; Li, F.; Duan, L.; Liu, C.; Lu, L.; Zhang, C.; Li, F. AtWuschel Promotes Formation of the Embryogenic Callus in Gossypium hirsutum. PLoS ONE 2014, 9, e87502. [Google Scholar] [CrossRef]
- Cosson, V.; Eschstruth, A.; Ratet, P. Medicago truncatula transformation using leaf explants. Methods Mol. Biol. 2015, 1223, 43–56. [Google Scholar] [CrossRef] [PubMed]
- Crane, C.; Dixon, R.A.; Wang, Z.Y. Medicago truncatula transformation using root explants. Methods Mol. Biol. 2006, 343, 137–142. [Google Scholar] [CrossRef]
- Rose, R.J. Somatic Embryogenesis in the Medicago truncatula Model: Cellular and Molecular Mechanisms. Front. Plant Sci. 2019, 10, 267. [Google Scholar] [CrossRef]
- Kyo, M.; Maida, K.; Nishioka, Y.; Matsui, K. Coexpression of WUSCHEL related homeobox (WOX) 2 with or WOX9 promotes regeneration from leaf segments and free cells in Nicotiana tabacum L. Plant Biotechnol. 2018, 35, 23–30. [Google Scholar] [CrossRef]
- Gaj, M.D. Factors influencing somatic embryogenesis induction and plant regeneration with particular reference to Arabidopsis thaliana. (L.) Heynh. Plant Growth Reg. 2004, 43, 27–47. [Google Scholar] [CrossRef]
- Trinh, T.H.; Ratet, P.; Kondorosi, E.; Durand, P.; Kamate, K.; Bauer, P.; Kondorosi, A. Rapid and efficient transformation of diploid Medicago truncatula and Medicago sativa ssp. falcata lines improved in somatic embryogenesis. Plant Cell Rep. 1998, 17, 345–355. [Google Scholar] [CrossRef] [PubMed]
- Häkkinen, S.T.; Moyano, E.; Cusidó, R.M.; Oksman-Caldentey, K.M. Exploring the metabolic stability of engineered hairy roots after 16 years maintenance. Front. Plant Sci. 2018, 7, 1486. [Google Scholar] [CrossRef]
- Reis, A.; Boutet-Mercey, S.; Massot, S.; Ratet, P.; Zuanazzi, J.A.S. Isoflavone production in hairy root cultures and plantlets of Trifolium pratense. Biotechnol. Lett. 2019, 41, 427–442. [Google Scholar] [CrossRef]
- Gomes, C.; Dupas, A.; Pagano, A.; Grima-Pettenati, J.; Paiva, J.A.P. Hairy Root transformation: A useful tool to explore gene function and expression in Salix spp. recalcitrant to transformation. Front. Plant Sci. 2019, 10, 1427. [Google Scholar] [CrossRef] [PubMed]
- Zhang, H.; Cao, Y.; Zhang, H.; Xu, Y.; Zhou, C.; Liu, W.; Zhu, R.; Shang, C.; Li, J.; Shen, Z.; et al. Efficient generation of CRISPR/Cas9-mediated homozygous/biallelic Medicago truncatula mutants using a hairy root system. Front. Plant Sci. 2020, 11, 294. [Google Scholar] [CrossRef] [PubMed]
- Elhiti, M.; Stasolla, C.; Wang, A. Molecular regulation of plant somatic embryogenesis. Cell. Dev. Biol. Plant. 2013, 49, 631–642. [Google Scholar] [CrossRef]
- Christensen, A.H.; Quail, P.H. Ubiquitin promoter-based vectors for high-level expression of selectable and/or screenable marker genes in monocotyledonous plants. Transgenic Res. 1996, 5, 213–218. [Google Scholar] [CrossRef]
- Pagny, S.; Cabanes-Macheteau, M.; Gillikin, J.W.; Leborgne-Castel, N.; Lerouge, P.; Boston, R.; Faye, L.; Gomord, V. Protein recycling from the Golgi apparatus to the endoplasmic reticulum is very active in plants but has a minor contribution to calreticulin retention. Plant Cell 2000, 12, 739–755. [Google Scholar] [CrossRef]
- Guerineau, F.; Benjdia, M.; Zhou, D.X. A jasmonate-responsive element within the A. thaliana vsp1 promoter. J. Exp. Bot. 2003, 54, 1153–1162. [Google Scholar] [CrossRef] [PubMed]
- Guerineau, F.; Woolston, S.; Brooks, L.; Mullineaux, P. An expression cassette for targeting foreign proteins into chloroplasts. Nucleic Acids Res. 1988, 16, 11380. [Google Scholar] [CrossRef][Green Version]
- Sambrook, J.; Fritschi, E.F.; Maniatis, T. Molecular Cloning: A Laboratory Manual; Cold Spring Harbor Laboratory Press: New York, NY, USA, 1989; p. 545. [Google Scholar]
- Hanahan, D.; Jessee, J.; Bloom, F.R. Plasmid transformation of Escherichia coli and other bacteria. Methods Enzymol. 1991, 20, 63–113. [Google Scholar]
- Vervliet., G.; Holsters, M.; Teuchy, H.; Van Montagu, M.; Schell, J. Characterization of different plaque forming and defective temperate phages in Agrobacterium strains. J. Gen. Virol. 1975, 26, 33–48. [Google Scholar] [CrossRef]
- Schenk, R.V.; Hildebrandt, A.C. Medium and Techniques for Induction and Growth of Monocotyledonous and Dicotyledonous Plant Cell Cultures. Can. J. Bot. 1972, 50, 199–204. [Google Scholar] [CrossRef]
- Hoffmann, B.; Trinh, T.H.; Leung, J.; Kondorosi, A.; Kondorosi, E. A new Medicago truncatula line with superior in vitro regeneration, transformation, and symbiotic properties isolated through cell culture selection. Mol. Plant Microbe Interact. 1997, 10, 307–315. [Google Scholar] [CrossRef]
- Boisson-Dernier, A.; Chabaud, M.; Garcia, F.; Bécard, G.; Rosenberg, C.; Barker, D.G. Hairy roots of Medicago truncatula as tools for studying nitrogen-fixing and endomycorrhizal symbioses. Mol. Plant Microbe Interact. 2001, 14, 693–700. [Google Scholar] [CrossRef]
- Fahraeus, G. The infection of clover root hairs by nodule bacteria studied by a simple glass slide technique. J. Gen. Microbiol. 1957, 16, 374–381. [Google Scholar] [CrossRef] [PubMed]
- Murashige, T.; Skoog, F. A revised medium for rapid growth and bio assays with tobacco tissue cultures. Physiol. Plant. 1962, 15, 473–497. [Google Scholar] [CrossRef]

Publisher’s Note: MDPI stays neutral with regard to jurisdictional claims in published maps and institutional affiliations. |
© 2021 by the authors. Licensee MDPI, Basel, Switzerland. This article is an open access article distributed under the terms and conditions of the Creative Commons Attribution (CC BY) license (https://creativecommons.org/licenses/by/4.0/).
Share and Cite
Kadri, A.; Grenier De March, G.; Guerineau, F.; Cosson, V.; Ratet, P. WUSCHEL Overexpression Promotes Callogenesis and Somatic Embryogenesis in Medicago truncatula Gaertn. Plants 2021, 10, 715. https://doi.org/10.3390/plants10040715
Kadri A, Grenier De March G, Guerineau F, Cosson V, Ratet P. WUSCHEL Overexpression Promotes Callogenesis and Somatic Embryogenesis in Medicago truncatula Gaertn. Plants. 2021; 10(4):715. https://doi.org/10.3390/plants10040715
Chicago/Turabian StyleKadri, Aline, Ghislaine Grenier De March, François Guerineau, Viviane Cosson, and Pascal Ratet. 2021. "WUSCHEL Overexpression Promotes Callogenesis and Somatic Embryogenesis in Medicago truncatula Gaertn" Plants 10, no. 4: 715. https://doi.org/10.3390/plants10040715
APA StyleKadri, A., Grenier De March, G., Guerineau, F., Cosson, V., & Ratet, P. (2021). WUSCHEL Overexpression Promotes Callogenesis and Somatic Embryogenesis in Medicago truncatula Gaertn. Plants, 10(4), 715. https://doi.org/10.3390/plants10040715

